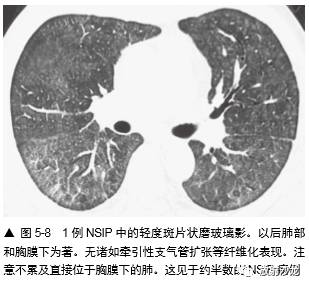

实质致密影,不管是局灶性、弥漫性或多灶性的肺衰减增加都是慢性肺病病例 HRCT 上的常 见表现。肺致密度或肺衰减增加一般描述为磨玻 璃影(GGO)或实变(图5-1)。有些肺部疾病可导致肺钙化或其他高衰减肺部异常。这些 都在本章内讨论。
磨玻璃影是一个非特异性术语,指HRCT上 肺密度模糊地增高,这有些随意性。它不掩蔽其 中的血管或支气管边缘(图 5-1 ~图 5-3),如果血管影被掩蔽了一般使用术语“实变”。该 表现反映多种异常,可见于气腔病变(图 5-3), 间质增厚(图 5-4),部分肺泡萎陷(肺不张), 毛细血管容量增加,或它们的组合。
磨玻璃影是形态性异常的平均容积太小,不 能在 HRCT 上清晰对比的结果。它反映“间 隔”或肺泡间质轻度增厚;肺泡壁增厚;间质炎症,浸润或纤维化,或有细胞或液体充盈部分肺 泡。当肺泡内有少量液体,像发生在气腔 充盈性病变的早期,液体倾向于在肺泡壁成层,在 HRCT 上不能与肺泡壁增厚区别。在一项22 例经活检证实的磨玻璃影者的 HRCT 和肺活检 的比较中,14% 的病变主要累及气腔,32% 有气 腔和间质混合异常,54% 主要为间质异常。部 分肺泡萎陷也导致肺衰减增加,形成磨玻璃影。
术语“磨玻璃影”可用于指毛细血管血容量 增加导致的肺密度增高,然而如果肺衰减异常的原因已知或可疑时,“马赛克灌注”一词则更为 合适。马赛克灌注的表现在第 7 章描述。
如磨玻璃影很轻微或弥漫分布,程度一致的累及全肺,则辨认困难。但磨玻璃影几乎总是呈片状分布,累及有些肺区,而不累及其他肺区。 这种肺实质的“地图样”表现很容易有信心地检 出和诊断(图5-3,图5-5)。在有些病例中,整 个肺小叶表现为异常致密,而邻近肺小叶正常。另一些病例的磨玻璃影呈小叶中心性和支气管周 围分布,形成边缘不清的小叶中心性结节。磨玻璃影可累及个别肺段和肺叶,也可累及不按肺段的肺区(图 5-6),或是弥漫的(图 5-7)。在肺区内出现表现“过黑”的含气支气管 也是有磨玻璃影的线索,这种黑色支气管表现本 质上是空气支气管征。











磨玻璃影有重要意义,因为它常说明有进行 性、活动性及潜在的可治疗的病变。在急性症状 的病例中,有磨玻璃影很可能伴有活动性病变。 例如,在AIDS 和急性呼吸窘迫病例中,HRCT 磨玻璃影可正确预测有耶氏孢子菌肺炎(前称卡氏孢子菌肺炎)。
在有亚急性或慢性症状的病例中,磨玻璃影 也提示活动性病变的可能,虽然此时肺纤维化也 能导致该表现。在 Leung 等的 22 例磨玻璃影病例 中,18 例(82%)经肺活检认为有活动性或潜 在的可治疗的病变。在Remy-Jardin 等的一项类似研究中,26 例的HRCT表现与37 处组织 学结果比较,37 处活检中的24 处(65%)磨玻 璃影符合有程度重于或等于纤维化的炎症。8 处 (22%)有炎症,但以纤维化为著。其余5处( 13%) 纤维化是唯一的组织学表现。因为有活动性病变, 磨玻璃影的存在常导致作进一步包括肺活检的诊断性评估,这取决于病例的临床状态。而且,当 做肺活检时,磨玻璃影区可作为外科医生或支气 管镜专家的靶。因为这些区域最可能是活动性的, 最可能取得有诊断性的材料。
因为磨玻璃影反映存在纤维化或炎症,诊断 时要小心,仅在不伴有HRCT 纤维化表现,或以 磨玻璃影为主要表现时诊断(图 5-5 ~图 5-8)。如磨玻璃影仅见于有牵引性支气管扩张或蜂窝等 HRCT 的纤维化改变的肺区内,纤维化可能将使 主要的组织学异常(图5-4,图5-9)。例如,在 Remy-Jardin 等的一项研究中,所有 HRCT 上的磨 玻璃影区内有牵引性支气管扩张或细支气管扩张 的病例,活检都有纤维化。然而,在不伴有牵引 性支气管扩张的磨玻璃影区的病例中,肺活检时 92% 发现有活动性炎症。

很多疾病HRCT 上有磨玻璃影。不少反映了 相似的累及肺泡间隔和肺泡腔炎症渗出的病变早 期或活动期的组织学表现,虽然这种表现可以是多种病理过程的结果。
当考虑磨玻璃影的鉴别诊断时,重要的是要知道病例的症状是急性、亚急性还是慢性的(表 5-1)。在这些磨玻璃影原因中,呈典型急性表现 的是肺水肿;肺出血(图5-2);各种肺炎,尤其是诸如耶氏孢子菌肺炎(PJP)(图 5-3, 图 5-7,图5-10)的非典型肺炎, 病毒性肺炎(如巨细胞病毒性),支原体肺炎;急性间质性肺炎(AIP)及其他原 因的弥漫性肺泡损伤(DAD)(图 5-6)和急性 呼吸窘迫综合征(ARDS),包括慢性间质性 肺炎的急性恶化;急性嗜酸性肺炎;急性过敏性肺炎,吸入性和早期放射性肺炎。


亚急性或慢性症状病例中磨玻璃影最常见的病因包括(表 5-1):间质性肺炎,如非特异性间 质性肺炎(NSIP)(图 5-8,图5-11),特发性 或其他特异性疾病,如硬皮病或其他胶原血管病,脱屑性间质性肺炎(DIP)(图 5-12) ,呼吸细支气管炎-间质性肺疾病(RB-ILD),过敏性肺炎(HP)(图 5-5,5-13), 机化性肺炎(OP),药物反应,慢 性嗜酸性肺炎(图 5-14),淋巴样间质性 肺炎(LIP),Churg-Strauss综合征, 类脂质肺炎(图5-15)和慢性或反复性吸入性肺炎,非黏液性和黏液性肺腺癌(图5-16) , 结节病,和肺泡蛋白沉着症(PAP)(图 5-17)。





在有磨玻璃影的病例中,组织学异常的类型 根据疾病的典型组织学表现而异,无特异性组织学改变(表 5-2)。在 NSIP、硬皮病或 其他胶原血管病病例中,许多研究曾结合CT 上 的磨玻璃影和活检结果、治疗反应和病例的生存期。在间质性肺炎病例的组织学研 究中曾显示,大部分磨玻璃影和肺泡壁或肺泡内炎症相关。例如,在一项Wells 等的硬皮病研究中,HRCT 上的致密度增加和7 例活检中4例的明显炎症相关,而在HRCT 上的网影中,13 例中12 例为纤维化。另一项14 例HRCT 表现为 磨玻璃影的特发性肺纤维化(IPF)病例中,活检 12 例有炎症。在寻常性间质性肺炎(UIP)病 例中,磨玻璃影伴有不等的肺纤维化;有磨玻璃 影的DIP 病例在很大程度上反映肺泡内有巨噬细胞。

 纵隔大细胞神经内分泌癌1例CT影像
纵隔大细胞神经内分泌癌1例CT影像  张力性纵隔气肿影像表现及严重度分级
张力性纵隔气肿影像表现及严重度分级  迅速增大的肺部结节,首先考虑良性,确诊需要肺穿
迅速增大的肺部结节,首先考虑良性,确诊需要肺穿  肺隔离症:易误诊为肺癌的占位性病变,肺穿刺禁忌!
肺隔离症:易误诊为肺癌的占位性病变,肺穿刺禁忌!  肺段与肺内管道应用解剖
肺段与肺内管道应用解剖  肺转移瘤的十种不典型CT表现
肺转移瘤的十种不典型CT表现  肺内淋巴结的CT表现特点及与病理对照
肺内淋巴结的CT表现特点及与病理对照  肺实变与肺不张的CT鉴别诊断
肺实变与肺不张的CT鉴别诊断  医生现身说法,这五种忙帮不得!
医生现身说法,这五种忙帮不得!  北大教授:要真正让医务人员有阳光体面的收入!医
北大教授:要真正让医务人员有阳光体面的收入!医  为值夜班的医生护士鼓与呼:请给我们更多关注!
为值夜班的医生护士鼓与呼:请给我们更多关注!  广东拟取消医院用药数量限制,满足患者多样性需求
广东拟取消医院用药数量限制,满足患者多样性需求  博士、硕士入职就给精装房!又有医院不惜下血本招
博士、硕士入职就给精装房!又有医院不惜下血本招  历时7年之久,温医生宣判无罪!
历时7年之久,温医生宣判无罪!  重磅!四川发文:严禁限制医生多点执业
重磅!四川发文:严禁限制医生多点执业  与真人医生诊断一致性达96%:AI医生应用前景广阔
与真人医生诊断一致性达96%:AI医生应用前景广阔 



